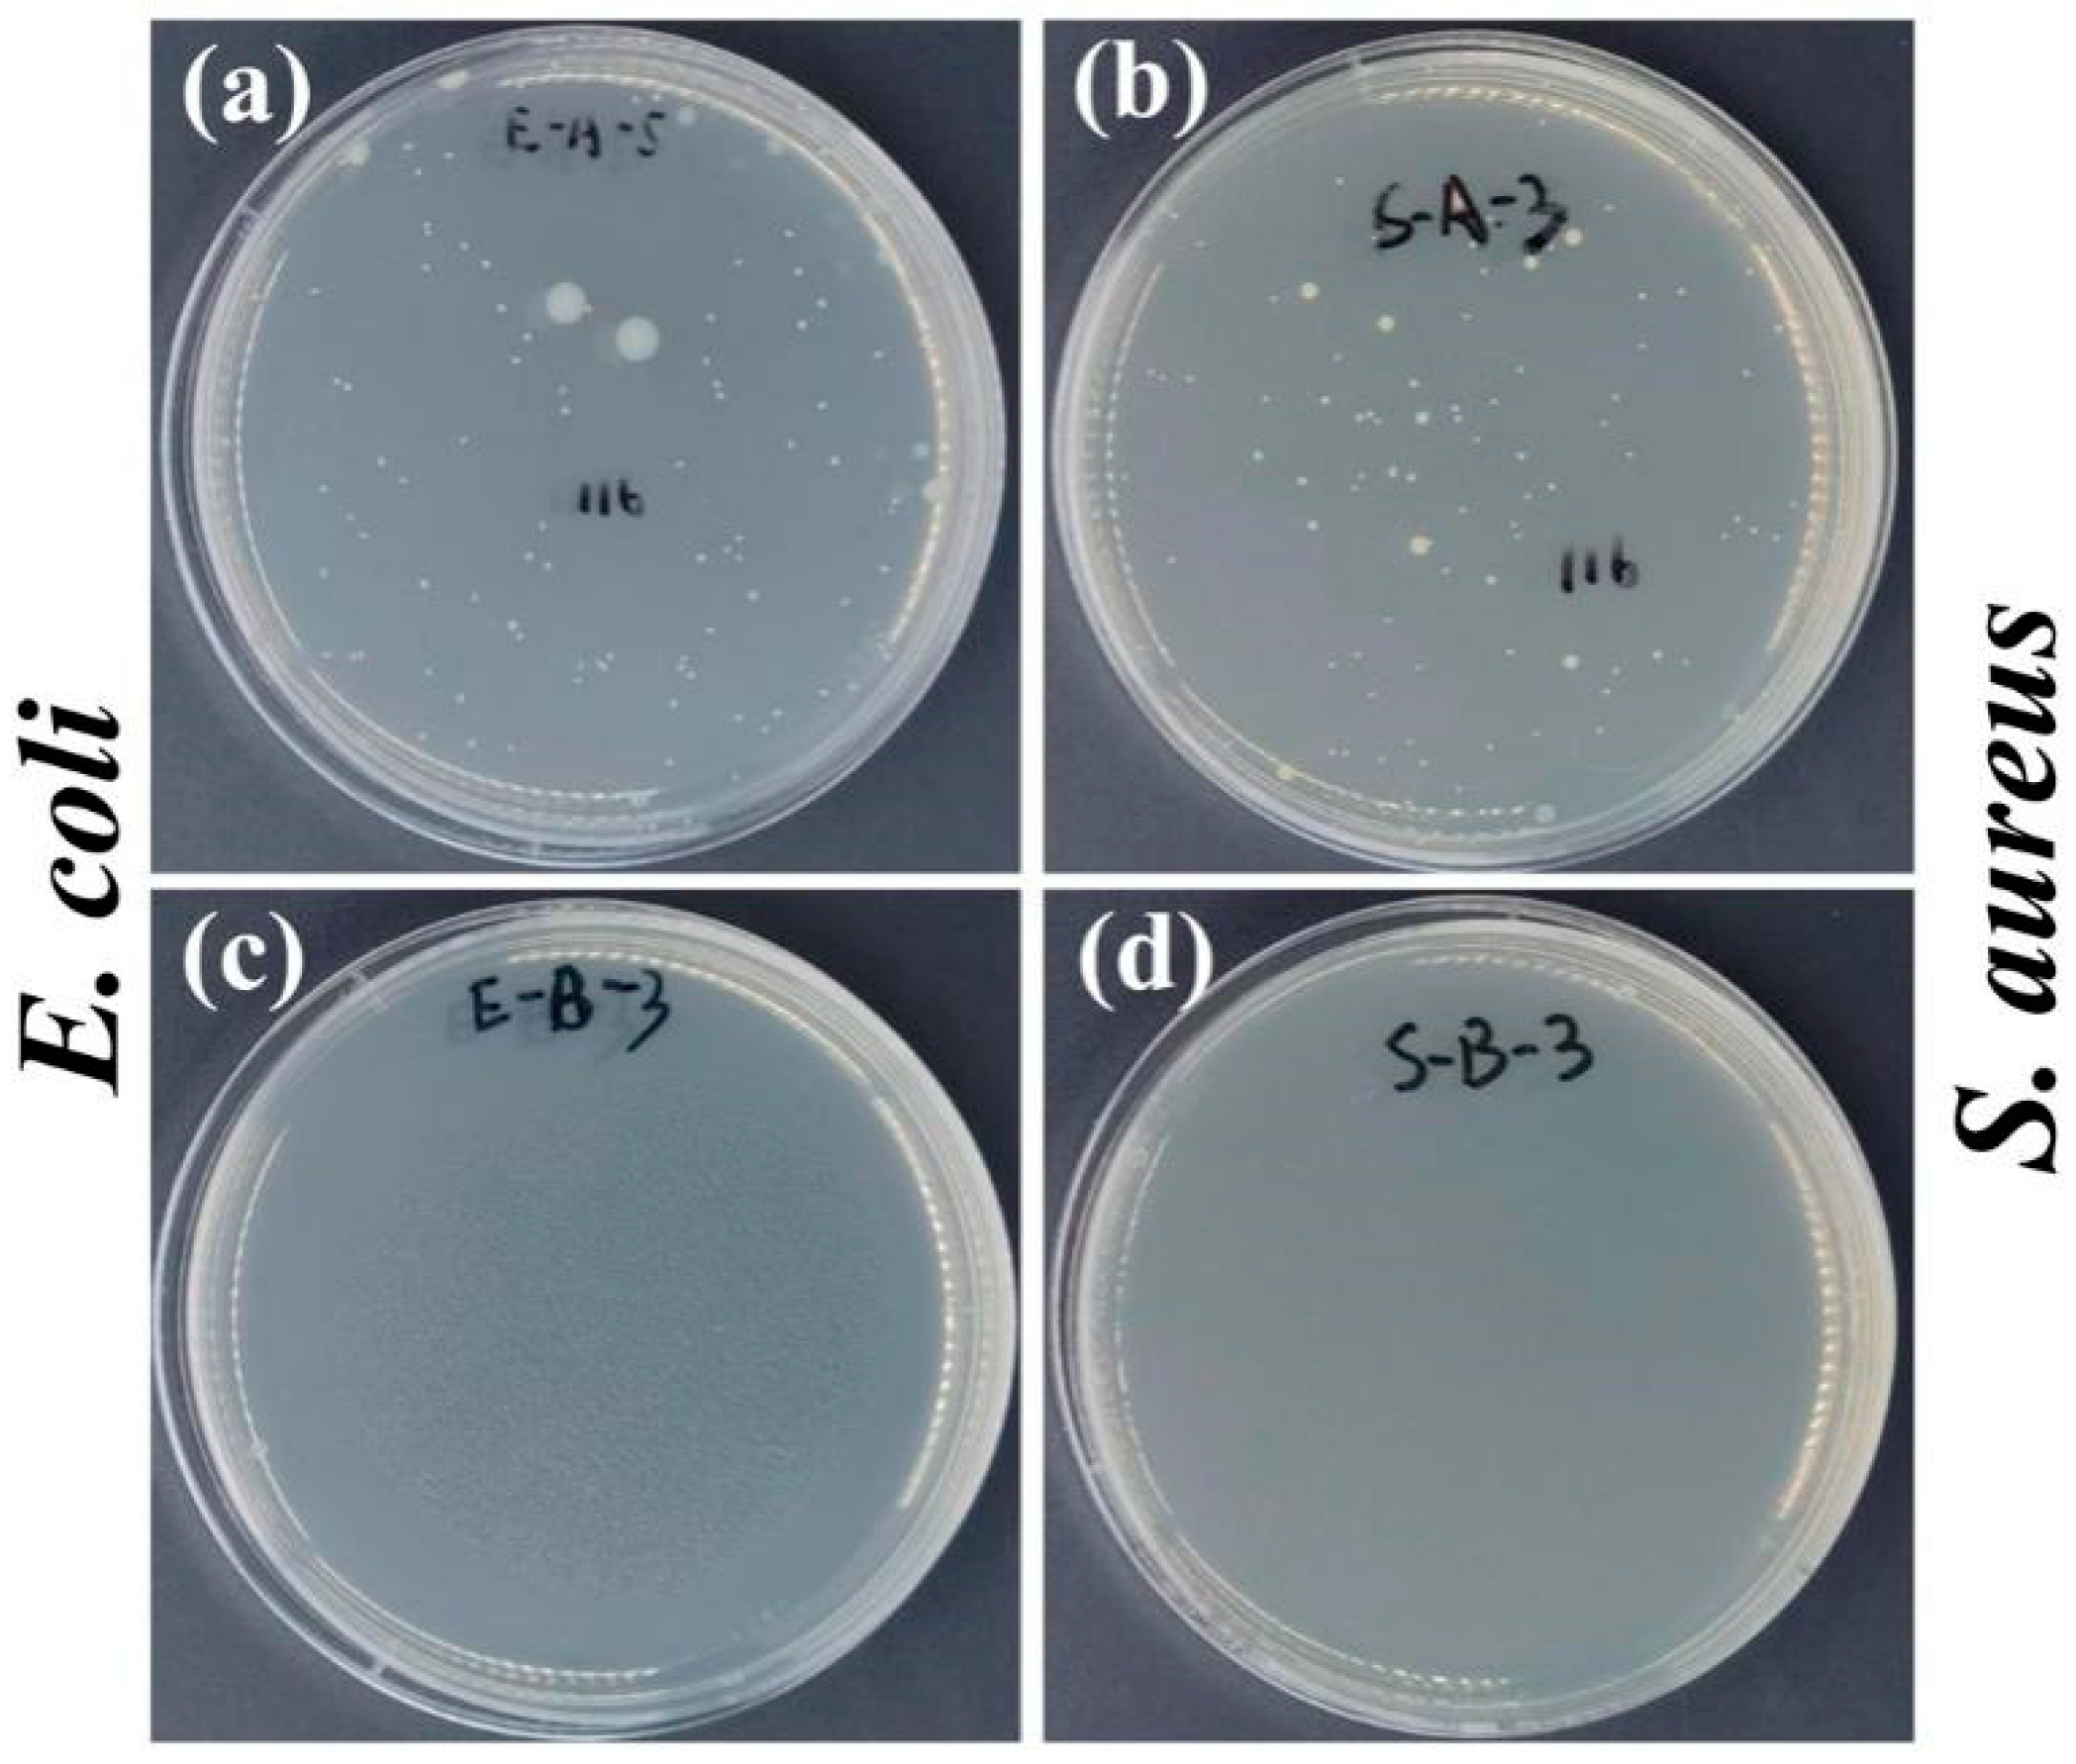
Polymers 16 03310 g009

Quaternized and Hyperbranched Amidoxime-Modified Ultra-High-Molecular-Weight Polyethylene Fiber for Uranium Extraction from Seawater
Abstract
1. Introduction
2. Materials and Methods
2.1. Materials
2.2. Preparation of UHMWPE Fibrous Adsorbent
2.2.1. Pre-Radiation Grafting Polymerization
2.2.2. Introduction of Poly-Amino Hyperbranched Structures and Quaternary Antimicrobial Groups
2.2.3. Introduction of Adsorption Groups
2.3. Uranium Adsorption Experiments
2.3.1. Uranium Adsorption in Aqueous Solution
2.3.2. Batch Uranium Adsorption in Simulated Seawater
2.4. Antibacterial Property
3. Results and Discussion
3.1. Characterization of the UHMWPE-g-PGAO Fiber
3.1.1. Chemical Structure and Morphology
3.1.2. Thermal Property
3.2. Uranium Adsorption
3.2.1. Impact of pH Levels on the Uranium Adsorption
3.2.2. Adsorption Kinetics
3.2.3. Isothermal Adsorption
3.2.4. Uranium Adsorption Tests in Simulated Seawater
3.2.5. Regeneration Performance
3.2.6. Antimicrobial Activity
3.2.7. Analysis of Adsorption Mechanism
4. Conclusions
Supplementary Materials
Author Contributions
Funding
Institutional Review Board Statement
Data Availability Statement
Conflicts of Interest
References
- Abney, C.W.; Mayes, R.T.; Saito, T.; Dai, S. Materials for the Recovery of Uranium from Seawater. Chem. Rev. 2017, 117, 13935–14013. [Google Scholar] [CrossRef] [PubMed]
- Yu, R.; Lu, Y.; Zhang, X.; Chen, W.; Chen, X.; Li, L. Amidoxime-modified ultrathin polyethylene fibrous membrane for uranium extraction from seawater. Desalination 2022, 539, 115965. [Google Scholar] [CrossRef]
- Alali, K.T.; Tan, S.; Zhu, J.; Liu, J.; Yu, J.; Liu, Q.; Wang, J. High mechanical property and hydrophilic electrospun poly amidoxime/poly acrylonitrile composite nanofibrous mats for extraction uranium from seawater. Chemosphere 2024, 351, 141191. [Google Scholar] [CrossRef] [PubMed]
- Xu, X.; Ding, X.J.; Ao, J.X.; Li, R.; Xing, Z.; Liu, X.Y.; Wu, G.Z.; Ma, H.J. Preparation of amidoxime-based PE/PP fibers for extraction of uranium from aqueous solution. Nucl. Sci. Tech. 2019, 30, 20. [Google Scholar] [CrossRef]
- Kuo, L.J.; Janke, C.J.; Wood, J.R.; Strivens, J.E.; Das, S.; Oyola, Y.; Mayes, R.T.; Gill, G.A. Characterization and Testing of Amidoxime-Based Adsorbent Materials to Extract Uranium from Natural Seawater. Ind. Eng. Chem. Res. 2015, 55, 4285–4293. [Google Scholar] [CrossRef]
- Jun, B.M.; Lee, H.K.; Park, S.; Kim, T.J. Purification of uranium-contaminated radioactive water by adsorption: A review on adsorbent materials. Sep. Purif. Technol. 2021, 278, 119675. [Google Scholar] [CrossRef]
- Pan, H.B.; Wai, C.M.; Kuo, L.J.; Wang, J.S.; Joshi, R.; Janke, C.J. A highly efficient uranium grabber derived from acrylic fiber for extracting uranium from seawater. Dalton Trans. 2020, 49, 2803–2810. [Google Scholar] [CrossRef]
- Mollick, S.; Saurabh, S.; More, Y.D.; Fajal, S.; Shirolkar, M.M.; Mandal, W.; Ghosh, S.K. Benchmark uranium extraction from seawater using an ionic macroporous metal–organic framework. Energy Environ. Sci. 2022, 15, 3462–3469. [Google Scholar] [CrossRef]
- Cui, W.R.; Li, F.F.; Xu, R.H.; Zhang, C.R.; Chen, X.R.; Yan, R.H.; Liang, R.P.; Qiu, J.D. Regenerable Covalent Organic Frameworks for Photo-enhanced Uranium Adsorption from Seawater. Angew. Chem. Int. Ed. 2020, 59, 17684–17690. [Google Scholar] [CrossRef]
- Cheng, G.; Zhang, A.; Zhao, Z.; Chai, Z.; Hu, B.; Han, B.; Ai, Y.; Wang, X. Extremely stable amidoxime functionalized covalent organic frameworks for uranium extraction from seawater with high efficiency and selectivity. Sci. Bull. 2021, 66, 1994–2001. [Google Scholar] [CrossRef]
- Tang, N.; Liang, J.; Niu, C.; Wang, H.; Luo, Y.; Xing, W.; Ye, S.; Liang, C.; Guo, H.; Guo, J.; et al. Amidoxime-based materials for uranium recovery and removal. J. Mater. Chem. A 2020, 8, 7588–7625. [Google Scholar] [CrossRef]
- Wang, C.Z.; Lan, J.H.; Wu, Q.Y.; Luo, Q.; Zhao, Y.L.; Wang, X.K.; Chai, Z.F.; Shi, W.Q. Theoretical insights on the interaction of uranium with amidoxime and carboxyl groups. Inorg. Chem. 2014, 53, 9466–9476. [Google Scholar] [CrossRef]
- Wu, Y.; Xie, Y.; Liu, X.; Li, Y.; Wang, J.; Chen, Z.; Yang, H.; Hu, B.; Shen, C.; Tang, Z.; et al. Functional nanomaterials for selective uranium recovery from seawater: Material design, extraction properties and mechanisms. Coord. Chem. Rev. 2023, 483, 215097. [Google Scholar] [CrossRef]
- Ahmed, B.; Ahmad, Z.; Ihsan, A.; Khan, M.A.; Fazal, T. Biomaterials as promising biosorbents for efficient uranium extraction from seawater: A comprehensive review. Sep. Purif. Technol. 2024, 338, 126507. [Google Scholar] [CrossRef]
- Lim, Y.J.; Goh, K.; Goto, A.; Zhao, Y.; Wang, R. Uranium and lithium extraction from seawater: Challenges and opportunities for a sustainable energy future. J. Mater. Chem. A 2023, 11, 22551–22589. [Google Scholar] [CrossRef]
- Hamza, M.F. Grafting of quaternary ammonium groups for uranium (VI) recovery: Application on natural acidic leaching liquor. J. Radioanal. Nucl. Chem. 2019, 322, 519–532. [Google Scholar] [CrossRef]
- Ao, J.; Han, J.; Xu, X.; Qi, S.; Ma, L.; Wang, Z.; Zhang, L.; Li, Q.; Xu, L.; Ma, H. Enhanced Performance in Uranium Extraction by Quaternary Ammonium-Functionalized Amidoxime-Based Fibers. Ind. Eng. Chem. Res. 2020, 59, 5828–5837. [Google Scholar] [CrossRef]
- Liu, L.; Chen, X.; Wang, P.; Ma, Y.; Wang, Y.; Dai, J.; Tian, X.; Pan, J. From flexible hyperbranched PEI to ultralight and elastic ordered-porous all-organic aerogel for effectively removing uranium. Sep. Purif. Technol. 2024, 338, 126584. [Google Scholar] [CrossRef]
- Ahmad, Z.; Li, Y.; Yang, J.; Geng, N.; Fan, Y.; Gou, X.; Sun, Q.; Chen, J. A Membrane-Supported Bifunctional Poly(amidoxime-ethyleneimine) Network for Enhanced Uranium Extraction from Seawater and Wastewater. J. Hazard. Mater. 2022, 425, 127995. [Google Scholar] [CrossRef]
- Huang, G.; Li, W.; Liu, Q.; Liu, J.; Zhang, H.; Li, R.; Li, Z.; Jing, X.; Wang, J. Efficient removal of uranium(vi) from simulated seawater with hyperbranched polyethylenimine (HPEI)-functionalized polyacrylonitrile fibers. New J. Chem. 2018, 42, 168–176. [Google Scholar] [CrossRef]
- Ahmad, Z.; Li, Y.; Huang, C.; Gou, X.; Fan, Y.; Chen, J. Underwater suspended bifunctionalized polyethyleneimine-based sponge for selective removal of anionic pollutants from aqueous solution. J. Hazard. Mater. 2021, 412, 125284. [Google Scholar] [CrossRef] [PubMed]
- Xing, Z.; Hu, J.; Wang, M.; Zhang, W.; Li, S.; Gao, Q.; Wu, G. Properties and evaluation of amidoxime-based UHMWPE fibrous adsorbent for extraction of uranium from seawater. Sci. China Chem. 2013, 56, 1504–1509. [Google Scholar] [CrossRef]
- Ren, W.N.; Feng, X.X.; He, Y.L.; Wang, M.L.; Hong, W.F.; Han, H.W.; Hu, J.T.; Wu, G.Z. Branched fibrous amidoxime adsorbent with ultrafast adsorption rate and high amidoxime utilization for uranium extraction from seawater. Nucl. Sci. Tech. 2023, 34, 90. [Google Scholar] [CrossRef]
- Yu, Q.; Yuan, Y.; Wen, J.; Zhao, X.; Zhao, S.; Wang, D.; Li, C.; Wang, X.; Wang, N. A Universally Applicable Strategy for Construction of Anti-Biofouling Adsorbents for Enhanced Uranium Recovery from Seawater. Adv. Sci. 2019, 6, 1900002. [Google Scholar] [CrossRef]
- Wen, J.; Li, Q.; Li, H.; Chen, M.; Hu, S.; Cheng, H. Nano-TiO2 Imparts Amidoximated Wool Fibers with Good Antibacterial Activity and Adsorption Capacity for Uranium (VI) Recovery. Ind. Eng. Chem. Res. 2018, 57, 1826–1833. [Google Scholar] [CrossRef]
- GB/T 20944; Textiles—Evaluation for Antibacterial Activity. China National Textile Industry Council: Beijing, China, 2007.
- Ma, H.; Yao, S.; Li, J.; Cao, C.; Wang, N. A mild method of amine-type adsorbents syntheses with emulsion graft polymerization of glycidyl methacrylate on polyethylene non-woven fabric by pre-irradiation. Radiat. Phys. Chem. 2012, 81, 1393–1397. [Google Scholar] [CrossRef]
- Kong, Z.Y.; Wei, J.F.; Li, Y.H.; Liu, N.N.; Zhang, H.; Zhang, Y.; Cui, L. Rapid removal of Cr (VI) ions using quaternary ammonium fibers functioned by 2-(dimethylamino)ethyl methacrylate and modified with 1-bromoalkanes. Chem. Eng. J. 2014, 254, 365–373. [Google Scholar] [CrossRef]
- Wang, D.; Song, J.; Wen, J.; Yuan, Y.; Liu, Z.; Lin, S.; Wang, H.; Wang, H.; Zhao, S.; Zhao, X.; et al. Significantly Enhanced Uranium Extraction from Seawater with Mass Produced Fully Amidoximated Nanofiber Adsorbent. Adv. Energy Mater. 2018, 8, 1802607. [Google Scholar] [CrossRef]
- Mathad, R.D.; Harish Kumar, H.G.; Sannakki, B.; Sanjeev, G.; Sarma, K.S.S.; Francis, S. Electron-beam-induced changes in ultra-high-molecular weight polyethylene. Radiat. Eff. Defects Solids Inc. Plasma Sci. Plasma Technol. 2010, 165, 277–289. [Google Scholar] [CrossRef]
- Hu, J.; Ma, H.; Xing, Z.; Liu, X.; Xu, L.; Li, R.; Lin, C.; Wang, M.; Li, J.; Wu, G. Preparation of Amidoximated Ultrahigh Molecular Weight Polyethylene Fiber by Radiation Grafting and Uranium Adsorption Test. Ind. Eng. Chem. Res. 2015, 55, 4118–4124. [Google Scholar] [CrossRef]
- Endrizzi, F.; Leggett, C.J.; Rao, L. Scientific Basis for Efficient Extraction of Uranium from Seawater. I: Understanding the Chemical Speciation of Uranium under Seawater Conditions. Ind. Eng. Chem. Res. 2016, 55, 4249–4256. [Google Scholar] [CrossRef]
- Ao, J.; Zhang, H.; Xu, X.; Yao, F.; Ma, L.; Zhang, L.; Ye, B.; Li, Q.; Xu, L.; Ma, H. A novel ion-imprinted amidoxime-functionalized UHMWPE fiber based on radiation-induced crosslinking for selective adsorption of uranium. Ind. Eng. Chem. Res. 2019, 9, 28588–28597. [Google Scholar] [CrossRef] [PubMed]
- Schenk, H.J.; Astheimer, L.; Witte, E.G.; Schwochau, K. Development of Sorbers for the Recovery of Uranium from Seawater. 1. Assessment of Key Parameters and Screening Studies of Sorber Materials. Sep. Sci. Technol. 1982, 17, 1293–1308. [Google Scholar] [CrossRef]
- Li, H.; He, N.; Cheng, C.; Dong, H.; Wen, J.; Wang, X. Antimicrobial polymer contained adsorbent: A promising candidate with remarkable anti-biofouling ability and durability for enhanced uranium extraction from seawater. Chem. Eng. J. 2020, 388, 124273. [Google Scholar] [CrossRef]
- Yu, Y.; Liu, J.; Liu, Q.; Chen, R.; Yu, J.; Zhu, J.; Wang, J. Quaternized polyethyleneimine-polyacrylonitrile crosslinked membrane with excellent performance synthetized by homogeneous strategy for efficient uranium extraction from seawater. Desalination 2023, 565, 116828. [Google Scholar] [CrossRef]
- Ma, D.; Xu, X.; Li, Z.; Peng, H.; Cai, D.; Wang, D.; Yue, Q. Nanoemulsion assembly toward vaterite mesoporous CaCO3 for high-efficient uranium extraction from seawater. J. Hazard. Mater. 2022, 432, 128695. [Google Scholar] [CrossRef]
- Li, L.; Li, H.; Lin, M.; Wen, J.; Hu, S. Effects of chain conformation on uranium adsorption performance of amidoxime adsorbents. Sep. Purif. Technol. 2023, 307, 122777. [Google Scholar] [CrossRef]

| Model-1 | Model-2 | ||||
|---|---|---|---|---|---|
| k1 (h−1) | Qe (mg/g) | R2 | k2 (g·mg−1·h−1) | Qe (mg/g) | R2 |
| 2.8 × 10−2 | 42.44 | 0.7659 | 7.6 × 10−4 | 85.47 | 0.9944 |
| Freundlich Model | Langmuir Model | ||||
|---|---|---|---|---|---|
| KF | 1/n | R2 | Qm (mg/g) | KL (L/mg) | R2 |
| 8.9 × 10−6 | 2.4473 | 0.4030 | 327.9 | 1.3737 | 0.9983 |
Disclaimer/Publisher’s Note: The statements, opinions and data contained in all publications are solely those of the individual author(s) and contributor(s) and not of MDPI and/or the editor(s). MDPI and/or the editor(s) disclaim responsibility for any injury to people or property resulting from any ideas, methods, instructions or products referred to in the content. |
© 2024 by the authors. Licensee MDPI, Basel, Switzerland. This article is an open access article distributed under the terms and conditions of the Creative Commons Attribution (CC BY) license (https://creativecommons.org/licenses/by/4.0/).
Share and Cite
Hu, L.; Han, H.; Mao, X.; Feng, X.; He, Y.; Hu, J.; Wu, G. Quaternized and Hyperbranched Amidoxime-Modified Ultra-High-Molecular-Weight Polyethylene Fiber for Uranium Extraction from Seawater. Polymers 2024, 16, 3310. https://doi.org/10.3390/polym16233310
Hu L, Han H, Mao X, Feng X, He Y, Hu J, Wu G. Quaternized and Hyperbranched Amidoxime-Modified Ultra-High-Molecular-Weight Polyethylene Fiber for Uranium Extraction from Seawater. Polymers. 2024; 16(23):3310. https://doi.org/10.3390/polym16233310
Chicago/Turabian StyleHu, Lijun, Hongwei Han, Xuanzhi Mao, Xinxin Feng, Yulong He, Jiangtao Hu, and Guozhong Wu. 2024. "Quaternized and Hyperbranched Amidoxime-Modified Ultra-High-Molecular-Weight Polyethylene Fiber for Uranium Extraction from Seawater" Polymers 16, no. 23: 3310. https://doi.org/10.3390/polym16233310
APA StyleHu, L., Han, H., Mao, X., Feng, X., He, Y., Hu, J., & Wu, G. (2024). Quaternized and Hyperbranched Amidoxime-Modified Ultra-High-Molecular-Weight Polyethylene Fiber for Uranium Extraction from Seawater. Polymers, 16(23), 3310. https://doi.org/10.3390/polym16233310

